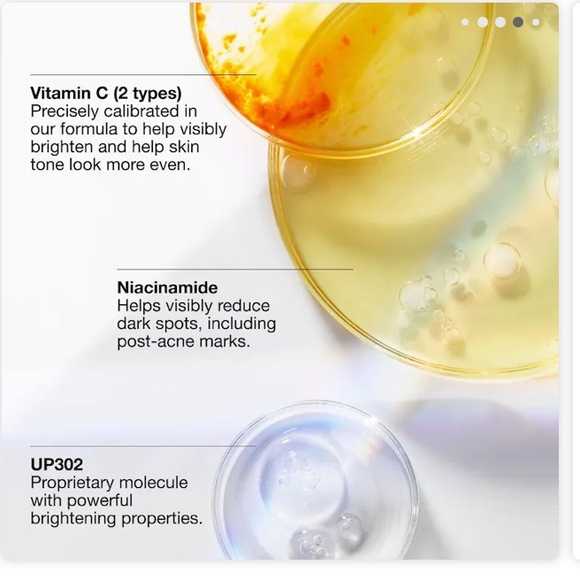
New Clinique Even Better Clinical Serum - Picture 4 of 8

New Clinique Even Better Clinical Serum
NWT
C$120 C$125
Size
Like and save for later
Add To Bundle
Achieve a radiant complexion with Clinique's Even Better Clinical Serum. This iridescent silver serum targets dark spots for a more even skin tone.
New
50 ml
Color
Shipping/Discount


boujeebeautyy
and
one other
like this
Trending Now
Find Similar Listings
Account is under Review
Comment posting is temporarily restricted. Our team will reach out to you shortly. To understand why, select
Learn More.